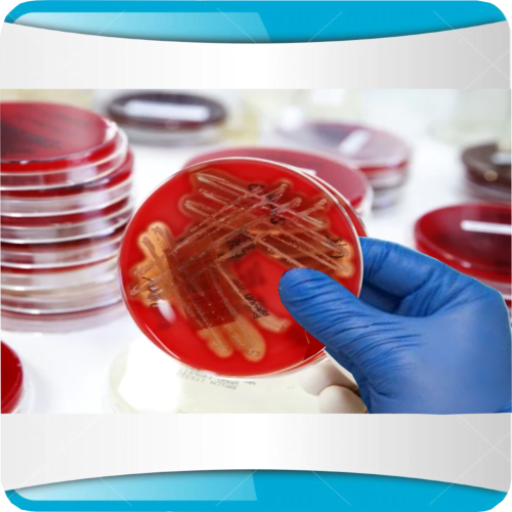
LA BACTÉRIOLOGIE MÉDICALE

LA BACTÉRIOLOGIE MÉDICALE PC
LALAOUNA ADEL
Download LA BACTÉRIOLOGIE MÉDICALE on PC With GameLoop Emulator
LA BACTÉRIOLOGIE MÉDICALE on PC
LA BACTÉRIOLOGIE MÉDICALE, coming from the developer LALAOUNA ADEL, is running on Android systerm in the past.
Now, You can play LA BACTÉRIOLOGIE MÉDICALE on PC with GameLoop smoothly.
Download it in the GameLoop library or search results. No more eyeing the battery or frustrating calls at the wrong time any more.
Just enjoy LA BACTÉRIOLOGIE MÉDICALE PC on the large screen for free!
LA BACTÉRIOLOGIE MÉDICALE Introduction
The application is a simulation of carrying out bacteriology examinations from sample collection to identification of the microbe
The application starts by opening a file for each sample
Then the sample is taken to the bench where the user ignites the benzene burner and selects and prepares the appropriate culture media.
After the seeding of the media is placed in the oven at 37C; the incubation time is fixed; and which is either short for learning or inspection purposes or for tracking purposes on real samples for live tracking.
After the incubation time has elapsed, the app gives an alert and the samples are extracted and collected for reading and comparison.
The app can compare most types of bacteria based on the nature of their growth and the interaction of the media placed on them.
Important Note: The app can perform multiple exams at once and track each sample separately
Exiting the app or turning off the phone does not affect media incubation time.
Tags
MedicalInformation
Developer
LALAOUNA ADEL
Latest Version
1.1.0.0
Last Updated
2022-05-31
Category
Medical
Available on
Google Play
Show More
How to play LA BACTÉRIOLOGIE MÉDICALE with GameLoop on PC
1. Download GameLoop from the official website, then run the exe file to install GameLoop
2. Open GameLoop and search for “LA BACTÉRIOLOGIE MÉDICALE” , find LA BACTÉRIOLOGIE MÉDICALE in the search results and click “Install”
3. Enjoy playing LA BACTÉRIOLOGIE MÉDICALE on GameLoop
Minimum requirements
OS
Windows 8.1 64-bit or Windows 10 64-bit
GPU
GTX 1050
CPU
i3-8300
Memory
8GB RAM
Storage
1GB available space
Recommended requirements
OS
Windows 8.1 64-bit or Windows 10 64-bit
GPU
GTX 1050
CPU
i3-9320
Memory
16GB RAM
Storage
1GB available space

